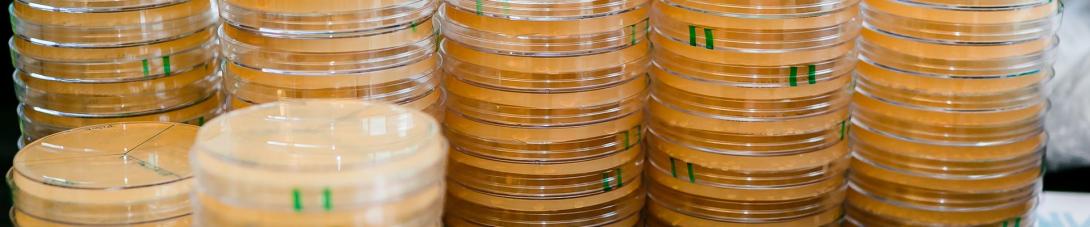

APHL/CDC Fellowships - Where are they now?
Wadsworth Center hosted 70 emerging infectious disease/infectious disease fellows through the APHL/CDC and NYSDOH WC fellowship programs between 1995 and 2021. The pie chart provides an overview of what these former fellows are doing presently. Many fellows have continued to work at the Wadsworth Center for the short term or the long term and many have gone off to further their education or work in a related public health or infectious disease field.